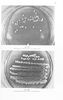

- Βουλή
- Μαθητικό Βοήθημα
- Γ' Μέσων Τεχνικών - Επαγγελματικών Σχολών
Ιωάννης Στασινόπουλος
Είδη Εργαστηριακών Εξετάσεων Τήρηση Αρχείου Γ' τάξη Επαγγελματικού Λυκείου
[1954]
Σχολικό εγχειρίδιο Γ' Μέσων Τεχνικών και Επαγγελματικών Σχολών που παρουσιάζει τεχνικές εργαστηριακών εξετάσεων, τρόπους τήρησης των αρχείων, και εγγραφή αποτελεσμάτων στα ιατρικά και βιομηχανικά εργαστήρια.
Μέτρηση και αναφορά αποτελεσμάτων
1Αποφυγή λάθους. Έντυπα απαντήσεων και αρχείο εργαστηρίου
10Η εξέταση των ούρων
15Βασικές βιοχημικές εξετάσεις
Γενικά περί αιματολογικών εξετάσεων
62Ορολογικές εξετάσεις
Βασικές μικροβιολογικές εξετάσεις
98Ειδικές εξετάσεις
Εγκεφαλωνιαίο υγρό
129Κόπρανα
132Πτύελα
135Αρθρικό υγρό
137Παθολογικά υγρά του σώματος
139
- ΠΕΔΙΟ ΑΝΑΓΝΩΡΙΣΗΣ »
- ΠΕΔΙΟ ΠΕΡΙΕΧΟΜΕΝΟΥ »
- ΠΕΔΙΟ ΠΛΗΡΟΦΟΡΙΩΝ ΕΚΔΟΣΗΣ »
- ΠΕΔΙΟ ΠΑΡΑΤΗΡΗΣΕΩΝ »
- ΕΥΡΕΤΗΡΙΟ ΘΕΜΑΤΙΚΩΝ ΟΡΩΝ »
| TopΠΕΔΙΟ ΑΝΑΓΝΩΡΙΣΗΣ |
|---|
Κωδικός αναγνώρισης: 03-20558279 Τίτλος: Είδη Εργαστηριακών Εξετάσεων Τήρηση Αρχείου Γ' τάξη Επαγγελματικού Λυκείου Συγγραφέας: Ιωάννης Στασινόπουλος Μέγεθος και υπόστρωμα: Μαθητικό βοήθημα, μαλακό εξώφυλλο, 150 σελίδες. Εικόνες, σκίτσα (έγχρωμα). |
| TopΠΕΔΙΟ ΠΕΡΙΕΧΟΜΕΝΟΥ |
Βαθμίδα εκπαίδευσης: Δευτεροβάθμια Τάξη: Γ' Μέσων Τεχνικών - Επαγγελματικών Σχολών Μάθημα: Εργαστηριακή Εξέταση Γλώσσα: Δημοτική Παρουσίαση περιεχομένου: Σχολικό εγχειρίδιο Γ' Μέσων Τεχνικών και Επαγγελματικών Σχολών που παρουσιάζει τεχνικές εργαστηριακών εξετάσεων, τρόπους τήρησης των αρχείων, και εγγραφή αποτελεσμάτων στα ιατρικά και βιομηχανικά εργαστήρια. |
| TopΠΕΔΙΟ ΠΛΗΡΟΦΟΡΙΩΝ ΕΚΔΟΣΗΣ |
Εκδότης: Ίδρυμα Ευγενίδου Έτος έκδοσης: 1954 Τόπος έκδοσης: Αθήνα |
| TopΠΕΔΙΟ ΠΑΡΑΤΗΡΗΣΕΩΝ |
Εντοπισμός πρωτοτύπου: Βιβλιοθήκη της Βουλής των Ελλήνων Κωδικός βιβλιοθήκης: 20558279 |
| TopΕΥΡΕΤΗΡΙΟ ΘΕΜΑΤΙΚΩΝ ΟΡΩΝ |
Σχετιζόμενα πρόσωπα: Σχετιζόμενοι όροι: |
LDR 01321 2200193 4500
035 ## _a03-20558279
040 ## _aΒιβλιοθήκη της Βουλής των Ελλήνων
041 ## _ael
100 ## _aΙωάννης Στασινόπουλος
110 ## _a20558279
245 0# _aΕίδη Εργαστηριακών Εξετάσεων Τήρηση Αρχείου Γ' τάξη Επαγγελματικού Λυκείου
260 ## _aΑθήνα
_bΊδρυμα Ευγενίδου
_c1954
300 ## _a150
_bΕικόνες, σκίτσα (έγχρωμα)
520 ## _aΣχολικό εγχειρίδιο Γ' Μέσων Τεχνικών και Επαγγελματικών Σχολών που παρουσιάζει τεχνικές εργαστηριακών εξετάσεων, τρόπους τήρησης των αρχείων, και εγγραφή αποτελεσμάτων στα ιατρικά και βιομηχανικά εργαστήρια.
521 ## _aΓ' Μέσων Τεχνικών - Επαγγελματικών Σχολών
522 ## _aΕλλάδα
546 ## _aΔημοτική
563 ## _aΜαλακό Εξώφυλλο
650 #4 _aΔείγματα
_aΔιαλύματα
_aΈνζυμα
_aΚυτταρολογική εξέταση
_aΜονάδες μέτρησης
_aΟργανικές ενώσεις
_aΣάκχαρο